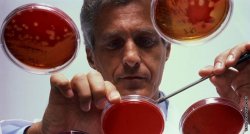
Возможные изменения в крови при химиотерапии

Негативные изменения в крови при химиотерапии встречаются не всегда. Однако в случае возникновения тех или иных проблем, существуют способы коррекции системы крови.
По сути Химиотерапия – часто неотъемлемая часть противоопухолевого лечения, которая может использоваться в комплексном лечении или как единственный метод терапии онкологического заболевания. Химиотерапия является системным видом лечения, то есть химиотерапевтические препараты циркулируют по всему организму. Таким образом, такой вид терапии имеет ряд побочных действий на различные системы органов. В этой статье мы поговорим о том, какие изменения могут отмечаться в системе крови при прохождении курса химиотерапии.
Химиотерапия – часто неотъемлемая часть противоопухолевого лечения, которая может использоваться в комплексном лечении или как единственный метод терапии онкологического заболевания. Химиотерапия является системным видом лечения, то есть химиотерапевтические препараты циркулируют по всему организму. Таким образом, такой вид терапии имеет ряд побочных действий на различные системы органов. В этой статье мы поговорим о том, какие изменения могут отмечаться в системе крови при прохождении курса химиотерапии.
Сразу оговоримся, что побочные явления от химиотерапии не носят систематический характер и в большинстве случаев являются временными. Тем не менее, информация о возможных осложнениях очень важна для пациента, поскольку это поможет ему лучше справляться с трудностями.
На протяжении первых 2-3 недель химиотерапия может вызвать уменьшение количества лейкоцитов, эритроцитов и тромбоцитов.
Нейтропения и лейкопенияНейтропения – это уменьшение количества определенных лейкоцитов. Как правило, такое явление при химиотерапии носит временный характер, и уровень лейкоцитов начинает постепенно подниматься уже на третьей неделе. В противном случае врач может принять решение об изменении назначенных доз химиотерапевтических средств или же назначить другой вид лечения для предотвращения появления инфекций.
В некоторых случаях химиотерапия может привести к уменьшению продукции лейкоцитов. Такое состояние называется лейкопенией, при которой снижаются возможности организма бороться с инфекцией. В этой связи, на протяжении данного периода необходимо придерживаться следующих рекомендаций:
- пить много жидкости (минимум 2 литра в сутки);
- избегать контактов с людьми, болеющих простудой, гриппом и другими инфекционными заболеваниями;
- защищайте себя от холода или жары;
- избегайте массовых мероприятий;
- старайтесь не пользоваться общественным транспортом, и пользуйтесь защитной маской;
- избегайте резких перепадов температур;
- избегайте контактов с животными, насекомыми и грязью;
- избегать всего, что может стать причиной развития аллергической реакции;
- избегать воздействия солнечных лучей;
- тщательно соблюдайте правила личной гигиены (регулярно мойте руки с мылом, отдавайте предпочтение электрической бритве);
- избегайте мелких порезов и травм.
Однако, невзирая на вышеперечисленные меры предосторожности, инфекция все же может возникнуть. Вот основные симптомы инфекционного процесса:
- температура тела выше 38,5 градусов; температура тела 38 градусов, которая держится более 24 часов; температура тела ниже 36,5 градусов;
- ночной пот и озноб;
- кашель, одышка и боль в груди;
- болевые ощущения при мочеиспускании и боль в мочевом пузыре;
- диарея (понос), которая длится несколько дней;
- отечность и покраснение в руках и ногах;
- воспаление в ротовой полости, появление язв;
- покраснения, отечность или боль в местах уколов.
При наличии вышеперечисленных симптомов обязательно обратитесь к своему врачу.
АнемияАнемия – состояние, при котором отмечается снижение уровня гемоглобина, часто при одновременном уменьшении количества красных кровяных телец (эритроцитов). Во время химиотерапии анемия носит временный характер, однако ее выявление очень важно для уменьшения симптомов, связанных с данным нарушением.
Основными проявлениями анемии являются:
- усталость, головокружение, заложенность в ушах;
- сниженное кровяное давление;
- боль в груди, одышка, ускоренное сердцебиение;
- бледность.
При диагностировании анемии назначаются специальные препараты, стимулирующие продукцию красных кровяных телец. Также может быть предложено переливание крови.
ТромбопенияТромбоциты – кровяные пластинки, позволяющие крови сворачиваться, формируя сгусток. При проведении курса химиотерапиинужно регулярно проводить анализы крови на уровень тромбоцитов. Если их уровень ниже нормы, то есть риск развития кровотечения. При внезапном кровотечении с носа, десен или появлении крови с калом нужно немедленно обратиться к врачу. Насторожить должны также синяки и яркие пятна, появляющиеся на коже.
АплазияЕсли во время химиотерапии одновременно снижается уровень эритроцитов, лейкоцитов и тромбоцитов, то в таком случае речь идет об аплазии. Аплазия развивается на 10-12 день химиотерапии. В некоторых случаях при аплазии показана госпитализация, дабы избежать ухудшения состояния и восстановить функции организма.



